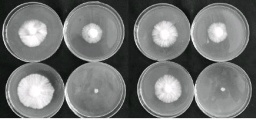

【机构】 福建农林大学生命科学学院菌物研究中心;
【摘要】 <正>金福菇(Tricholoma lobayense Heim)是一种高温型ManBetX体育,适合夏季出菇。它与草菇、灵芝、毛木耳等高温型或中高温型ManBetX体育一样,菌种在低温(4℃)下保藏,经常出现菌种死亡问题,而在室温下保藏则易出现菌种老化。菌种保藏的目的是保持良种的优良种性,它是良种保护的重要环节。一般地,菌种处于生长状态,易出现老化,也易发生变异,菌种保藏技术研究就是为了 ……
Manbetx体育手机版推荐A9版本 金福菇; 液氮保藏; 降温速率; 解冻温度; 保藏温度;
【文内图片】
不同程序降温保藏的菌种生长情况
【基金】 国家星火计划项目“ManBetX体育产业升级与可持续发展技术体系示范”(项目编号2011GA720008)
【分类号】S646





